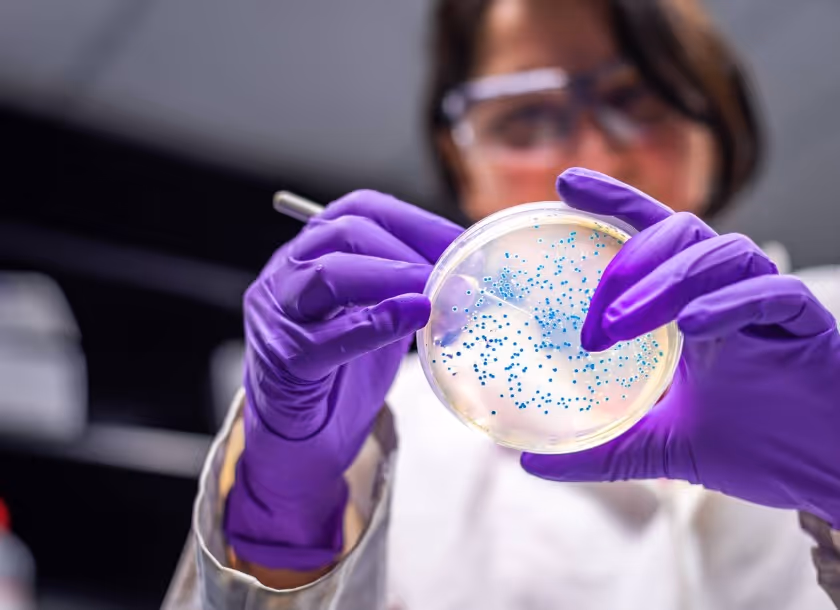

Blog da Afya
O maior grupo de educação e soluções médicas do Brasil.
Resultados para todos
.avif)
4
m de leitura
•
05.02.2026
Surto de Febre Maculosa: tudo o que você precisa saber sobre a doença

4
m de leitura
•
05.02.2026
Surto de dengue: cuidado com os riscos da automedicação
5
m de leitura
•
05.02.2026
Superbactérias: o que são, como surgem e novos métodos para combatê-las
.avif)
4
m de leitura
•
05.02.2026
Superfecundação heteroparental: como é possível engravidar de “dois pais” ao mesmo tempo?

4
m de leitura
•
05.02.2026
Superação: médicos com deficiência encontram espaço no mercado

6
m de leitura
•
05.02.2026
7 subespecialidades cirúrgicas mais procuradas pelos médicos

6
m de leitura
•
05.02.2026
12 soluções não-convencionais para melhorar a saúde

8
m de leitura
•
05.02.2026
15 sites para estudantes de Medicina que você precisa conhecer
.avif)
3
m de leitura
•
23.10.2025
Soft skills: conheça as mais importantes para o estudante de Medicina
Sugestão para você ler
Continue explorando
Pesquise ou clique no tema do seu interesse abaixo:

Venha estudar Medicina com quem mais entende de formação médica no Brasil
- O maior ecossistema de educação médica do Brasil
- +20.000 alunos de Medicina
- +30 anos de tradição



